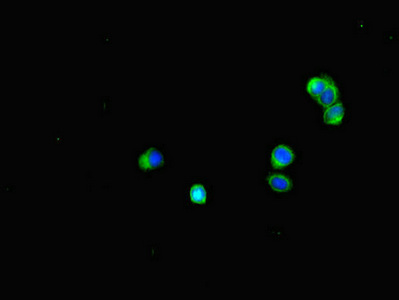

BUB1B Antibody
-
中文名稱:BUB1B兔多克隆抗體
-
貨號(hào):CSB-PA002883LA01HU
-
規(guī)格:¥440
-
圖片:
-
Immunohistochemistry of paraffin-embedded human endometrial cancer using CSB-PA002883LA01HU at dilution of 1:100
-
Immunofluorescent analysis of HepG2 cells using CSB-PA002883LA01HU at dilution of 1:100 and Alexa Fluor 488-congugated AffiniPure Goat Anti-Rabbit IgG(H+L)
-
Immunoprecipitating BUB1B in JK whole cell lysate
Lane 1: Rabbit control IgG (1μg) instead of CSB-PA002883LA01HU in Jurkat whole cell lysate. For western blotting, a HRP-conjugated Protein G antibody was used as the secondary antibody (1/2000)
Lane 2: CSB-PA002883LA01HU (6μg) + JK whole cell lysate (500μg)
Lane 3: JK whole cell lysate (10μg)
-
-
其他:
產(chǎn)品詳情
-
產(chǎn)品名稱:Rabbit anti-Homo sapiens (Human) BUB1B Polyclonal antibody
-
Uniprot No.:
-
基因名:
-
別名:Beta homolg of S. cerevisiae BUB 1 antibody; Beta homolg of S. cerevisiae budding uninhibited by benzimidazoles antibody; BUB 1B antibody; BUB1 budding uninhibited by benzimidazoles 1 homolog beta antibody; Bub1A antibody; BUB1B antibody; BUB1B_HUMAN antibody; BUB1beta antibody; BUBR1 antibody; Budding Uninhibited by Benzimidazoles 1 beta antibody; Budding uninhibited by benzimidazoles 1 homolog beta (yeast) antibody; hBUBR1 antibody; MAD3/BUB1 related protein kinase antibody; MAD3/BUB1-related protein kinase antibody; MAD3L antibody; Mitotic checkpoint gene BUB1B antibody; Mitotic checkpoint kinase MAD3L antibody; Mitotic checkpoint serine/threonine protein kinase BUB1 beta antibody; Mitotic checkpoint serine/threonine-protein kinase BUB1 beta antibody; MVA1 antibody; OTTHUMP00000160319 antibody; Protein SSK1 antibody; SSK 1 antibody; SSK1 antibody
-
宿主:Rabbit
-
反應(yīng)種屬:Human
-
免疫原:Recombinant Human Mitotic checkpoint serine/threonine-protein kinase BUB1 beta protein (230-394AA)
-
免疫原種屬:Homo sapiens (Human)
-
標(biāo)記方式:Non-conjugated
本頁面中的產(chǎn)品,BUB1B Antibody (CSB-PA002883LA01HU),的標(biāo)記方式是Non-conjugated。對(duì)于BUB1B Antibody,我們還提供其他標(biāo)記。見下表:
-
克隆類型:Polyclonal
-
抗體亞型:IgG
-
純化方式:>95%, Protein G purified
-
濃度:It differs from different batches. Please contact us to confirm it.
-
保存緩沖液:Preservative: 0.03% Proclin 300
Constituents: 50% Glycerol, 0.01M PBS, PH 7.4 -
產(chǎn)品提供形式:Liquid
-
應(yīng)用范圍:ELISA, IHC, IF, IP
-
推薦稀釋比:
Application Recommended Dilution IHC 1:20-1:200 IF 1:50-1:500 IP 1:200-1:2000 -
Protocols:
-
儲(chǔ)存條件:Upon receipt, store at -20°C or -80°C. Avoid repeated freeze.
-
貨期:Basically, we can dispatch the products out in 1-3 working days after receiving your orders. Delivery time maybe differs from different purchasing way or location, please kindly consult your local distributors for specific delivery time.
-
用途:For Research Use Only. Not for use in diagnostic or therapeutic procedures.
相關(guān)產(chǎn)品
靶點(diǎn)詳情
-
功能:Essential component of the mitotic checkpoint. Required for normal mitosis progression. The mitotic checkpoint delays anaphase until all chromosomes are properly attached to the mitotic spindle. One of its checkpoint functions is to inhibit the activity of the anaphase-promoting complex/cyclosome (APC/C) by blocking the binding of CDC20 to APC/C, independently of its kinase activity. The other is to monitor kinetochore activities that depend on the kinetochore motor CENPE. Required for kinetochore localization of CENPE. Negatively regulates PLK1 activity in interphase cells and suppresses centrosome amplification. Also implicated in triggering apoptosis in polyploid cells that exit aberrantly from mitotic arrest. May play a role for tumor suppression.
-
基因功能參考文獻(xiàn):
- Human gastric cancer tissues with low BUBR1 expression showed no eNOS expression. A decrease in BUBR1 reduced eNOS bioavailability through a pathway other than eNOS phosphorylation. PMID: 30396924
- Authors show that two distinct pools of BubR1/Bub3 exist at kinetochores and we uncouple these with defined BubR1/Bub3 mutants to address their function. PMID: 27457023
- we found that FOXM1 inhibitor attenuated tumorigenesis and radioresistance of glioblastoma (GBM) both in vitro and in vivo. Altogether, BUB1B promotes tumor proliferation and induces radioresistance in GBM, indicating that BUB1B could be a potential therapeutic target for GBM. PMID: 29039578
- Results from phylogenomic study identified of a novel conserved cassette of short linear motifs in BubR1 essential for the spindle checkpoint PMID: 28003474
- BubR1 N-terminal domain was necessary, but not sufficient to protect against aneuploidy and cancer. In contrast, BubR1 lacking the internal Cdc20-binding domain provided protection against both, which coincided with improved microtubule-kinetochore attachment error correction and spindle assembly checkpoint activity. PMID: 27528194
- Low BUB1B expression is associated with Chromophobe Renal Cell Carcinomas. PMID: 28807937
- Whether carriers of pathogenic BUB1B mutations, such as the parents of MVA syndrome patients, have an increased risk for cancer remains of interest, as studies in mice have suggested that haploinsufficiency of BUB1B may cause an increase in carcinogen-induced tumors PMID: 27239782
- structure of the PP2A B56-BubR1 complex provides important insights into how the B56 subunit directs the recruitment of PP2A to specific targets. PMID: 27350047
- Overexpression of BUB1B is associated with Invasive Breast Cancer. PMID: 27165245
- we showed that BubR1 and Mad2 are overexpressed in oral squamous cell carcinoma cell lines and linked such overexpression to attenuated spindle assembly checkpoint activity. We also showed BubR1 overexpression to be associated with advanced stage and tumour size. PMID: 25754611
- The integrity of the mitotic checkpoint complex depends on the specific recognition between BubR1 and Bub3, for which the BubR1 Gle2 binding sequence motif is essential. PMID: 27030009
- We show that kinetochore recruitment of BUBR1 and BUB3 by BUB1 is dispensable for SAC activation PMID: 26148513
- Data suggest that both BubR1 and SNCG may be promising predictive marker rather than prognostic marker in patients with breast cancer. PMID: 26191236
- BubR1 knockdown significantly decreased cellular invasion but slightly affect cellular proliferation on both Ca9-22 and Cal-27 cells. PMID: 26151845
- BubR1 contributes to preventing premature aging. [review] PMID: 25964054
- Suggest human papillomavirus E2 protein provokes BUBR1-dependent aneuploidy in HPV-induced cervical cancer. PMID: 25789401
- In conclusion, the results presented here suggest that Mad2 and BubR1 could be used as prognostic markers of tumor progression and new pharmacological targets in the treatment for gastric cancer . PMID: 25483095
- Co-depletion of MAD2 and BUBR1 causes cell cycle arrest and cell death in addition to aneuploidy. PMID: 24687487
- By sequestering PIDD at the kinetochore, BubR1 acts to delay PIDDosome formation until the next cycle, defining a new mechanism by which cells evade apoptosis during mitosis. PMID: 25936804
- a Cdc20 binding site in BubR1 facilitates both spindle assembly checkpoint signalling and silencing PMID: 25482201
- study shows that SIRT2 is a deacetylase for BubR1 K250, although the abnormally prolonged SAC activation observed in SIRT2 knockdown cells is not accompanied by a change in BubR1 levels or by delayed progression from prometaphase to anaphase PMID: 25285631
- YAP constitutively associated with BubR1 (BUB1-related protein kinase), and knockdown of BubR1 relieved YAP-driven hyperactivation of the spindle checkpoint. PMID: 25605730
- Data indicate that cell cycle protein Bub3-mediated kinetochore recruitment of BubR1 kinase enhances mitotic checkpoint signaling. PMID: 25246557
- the BubR1M-Cdc20 interaction indirectly contributes to mitotic checkpoint complex homeostasis PMID: 25505175
- The ABBA motif in cyclin A is required for its proper degradation in prometaphase through competing with BUBR1 for the same site on CDC20 PMID: 25669885
- Our findings indicated an interplay between BUBR1 and p53 in colorectal cancer. Altered expression of both molecules was associated with chromosomal instability. PMID: 25275037
- the loss of BubR1 levels with age is due to a decline in NAD(+) and the ability of SIRT2 to maintain lysine-668 of BubR1 in a deacetylated state, which is counteracted by the acetyltransferase CBP. PMID: 24825348
- In acute myeloid leukemia, repression of BubR1 is associated with enhanced anaphase-promoting complex activity. PMID: 23812934
- p53 deficiency may lead to the failure of BubR1 downregulation by OS and that p53 deficiency and BubR1 accumulation could contribute to gastric carcinogenesis associated with aneuploidy. PMID: 24156017
- BubR1 overexpression was associated with cell proliferation and may play a role in the carcinogenesis of gastrointestinal diffuse large B cell lymphoma PMID: 23400934
- These results suggest that the malignant transformation of plexiform neurofibroma is associated with distinct changes in the expression of BUB1B, PBK and NEK2 PMID: 23370767
- High levels of BubR1 were less sensitive to the anti-microtubule drugs paclitaxel and nocodazole in esophageal squamous cell carcinoma. PMID: 23128493
- Data suggest that BubR1 counteracts Aurora B kinase activity at improperly attached kinetochores by recruiting B56-PP2A phosphatase complexes. PMID: 23345399
- Reduced BubR1 expression is strongly associated with longer survival in prostate cancer patients. PMID: 23475578
- Mad2 Binding Induces a Functional Switch in Cdc20,Enabling BubR1 Binding. PMID: 23791783
- findings highlight the insufficiency of BUB1 haploinsufficiency to directly stimulate tumourigenesis, and suggest that other factors may be more critical to this process. PMID: 23440991
- Rsf-1 increases the frequency of abnormal mitotic events by disrupting hBubR1-Cdc20 interactions. PMID: 23536579
- Results suggest that targeting the GLEBS domain activity of BUB1B may provide a therapeutic window for glioblastoma. PMID: 23154965
- Elevated BUBR1 expression was associated with poor survival in early stage breast cancer patients PMID: 23392733
- The PLK1 and BUBR1 cooperate to stabilize kinetochore-microtubule interactions by regulating PP2A-B56alpha-mediated dephosphorylation of Aurora B substrates at the kinetochore-microtubule interface. PMID: 23079597
- It was shown that the state of CENP-E-dependent BubR1 autophosphorylation in response to spindle microtubule capture by CENP-E is important for kinetochore function in achieving accurate chromosome segregation. PMID: 22801780
- Results reveal that BubR1 sumoylation plays an important role in its timely removal from the kinetochores and the checkpoint inactivation, thus allowing normal anaphase entry and chromosome segregation. PMID: 22374677
- It was shown that Mad3/BUBR1 and BUB1 paralogous pairs arose by nine independent gene duplications throughout evolution. It was also shown that putative catalysis by human BUBR1 is dispensable for error-free chromosome segregation. PMID: 22698286
- p31(comet) negatively regulates the spindle assembly checkpoint by extracting Mad2 from the MCC. PMID: 22100920
- a new type of post-translational modification that is essential for BubR1 function during mitosis. PMID: 22167194
- we identify the Blinkin motif critical for interaction with BUBR1, define the stoichiometry and affinity of the interaction, and present a 2.2 Angstrom resolution crystal structure of the complex PMID: 22000412
- DLGAP5-PINK1 and BUB1B-PINK1 were strong predictors of disease-free survival and overall survival, respectively, among adult patients with ACT. PMID: 22048964
- Aging-related loss of BubR1 and subsequent impairment of reactivity to reactive oxygen species may explain reduced proliferative capacity of aged smooth muscle cells. PMID: 21550059
- Our data imply the possibility that BUBR1 may be involved in the progression of oral squamous cell carcinoma, and suggest that BUBR1 may be a promising prognostic marker in patients with OSCC PMID: 21069850
- BUBR1 and closed MAD2 (C-MAD2) interact directly to assemble a functional mitotic checkpoint complex PMID: 21525009
顯示更多
收起更多
-
相關(guān)疾病:Premature chromatid separation trait (PCS); Mosaic variegated aneuploidy syndrome 1 (MVA1)
-
亞細(xì)胞定位:Cytoplasm. Nucleus. Chromosome, centromere, kinetochore. Cytoplasm, cytoskeleton, microtubule organizing center, centrosome. Note=Cytoplasmic in interphase cells. Associates with the kinetochores in early prophase. Kinetochore localization requires BUB1, PLK1 and KNL1.
-
蛋白家族:Protein kinase superfamily, Ser/Thr protein kinase family, BUB1 subfamily
-
組織特異性:Highly expressed in thymus followed by spleen. Preferentially expressed in tissues with a high mitotic index.
-
數(shù)據(jù)庫鏈接:
Most popular with customers
-
-
YWHAB Recombinant Monoclonal Antibody
Applications: ELISA, WB, IHC, IF, FC
Species Reactivity: Human, Mouse, Rat
-
Phospho-YAP1 (S127) Recombinant Monoclonal Antibody
Applications: ELISA, WB, IHC
Species Reactivity: Human
-
-
-
-
-